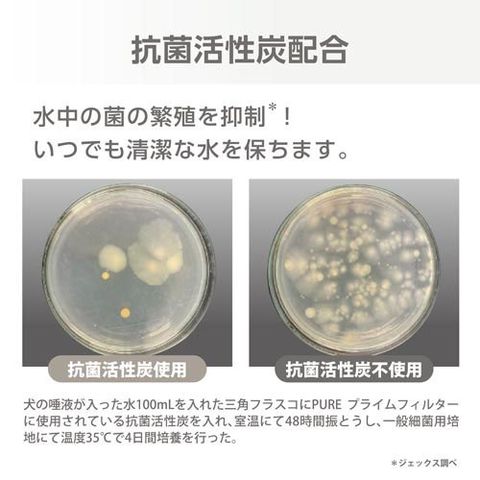

6/13
時点_ポイント最大10倍
PURE ウォーターファウンテン プライムフィルター (5個入り)
販売価格
2,508
円 (税込)
- 出荷目安:
- 取り寄せ商品(通常1週間-10日)
たまるdポイント(通常) 22
+キャンペーンポイント(期間・用途限定) 最大9倍
※たまるdポイントはポイント支払を除く商品代金(税抜)の1%です。
※表示倍率は各キャンペーンの適用条件を全て満たした場合の最大倍率です。
各キャンペーンの適用状況によっては、ポイントの進呈数・付与倍率が最大倍率より少なくなる場合がございます。
dカードでお支払ならポイント3倍
各キャンペーンの適用状況によっては、ポイントの進呈数・付与倍率が最大倍率より少なくなる場合がございます。
- 商品情報
- レビュー
こちらの商品は、ペット用の商品です。
【発売元、製造元、輸入元又は販売元】
GEX(ジェックス)
リニューアルに伴い、パッケージ・内容等予告なく変更する場合がございます。予めご了承ください。
【PURE ウォーターファウンテン プライムフィルターの商品詳細】
●抗菌活性炭たっぷり配合(メーカー内製品比):キレイを維持・カルキ臭を吸着しおいしい水に
●下部尿路の健康維持に:マグネシウム・カルシウムを除去して軟水に
●不織布:ふわふわ繊維が食べカス・抜け毛・ホコリをからめとって離さない本製品はPUREウォーターファウンテン・ピュアクリスタル専用です。
●他の目的には使用しないでください。
●子供・認知症の方の手の触れない場所に保管してください。
●子供にセットさせる場合は、大人の監視のもとで行ってください。
●直射日光・高温多湿を避けて保管してください。
【使用方法】
1.水道水をためた容器にフィルターを沈め、数回揺すり洗いをくり返して活性炭の微粉やイオン交換樹脂の黄色の水が出なくなるまで洗い流します。
2.フィルターの不織布側を上に向けて、ファウンテンにセットします。
・フィルターのお手入れには洗剤は使用せず、流水で表面の汚れを洗い流してください。
・夏場は虫が発生する可能性がありますので、毎日の洗浄をおすすめします。
・健康維持のため、フィルターは3週間から1ヶ月をめどに、または抜け毛やフードカスなどの目に見える汚れや変色が目立ってきたら交換してください。
・フィルター交換時には、清潔に保つために必ずファウンテン本体各部・ポンプを洗浄してください。
【規格概要】
【注意事項】
・抗菌活性炭にはフィルターがピンク色になることを抑制する効果はありません。
・使用環境によってはフィルターがピンク色になる場合がありますが、ペットに害はありません。
・使用中、やや黄色がかった水が出ることがありますが、これはイオン交換樹脂の成分が溶出するためであり、品質には問題なく無害です。
【発売元、製造元、輸入元又は販売元】
GEX(ジェックス)
リニューアルに伴い、パッケージ・内容等予告なく変更する場合がございます。予めご了承ください。
【PURE ウォーターファウンテン プライムフィルターの商品詳細】
●抗菌活性炭たっぷり配合(メーカー内製品比):キレイを維持・カルキ臭を吸着しおいしい水に
●下部尿路の健康維持に:マグネシウム・カルシウムを除去して軟水に
●不織布:ふわふわ繊維が食べカス・抜け毛・ホコリをからめとって離さない本製品はPUREウォーターファウンテン・ピュアクリスタル専用です。
●他の目的には使用しないでください。
●子供・認知症の方の手の触れない場所に保管してください。
●子供にセットさせる場合は、大人の監視のもとで行ってください。
●直射日光・高温多湿を避けて保管してください。
【使用方法】
1.水道水をためた容器にフィルターを沈め、数回揺すり洗いをくり返して活性炭の微粉やイオン交換樹脂の黄色の水が出なくなるまで洗い流します。
2.フィルターの不織布側を上に向けて、ファウンテンにセットします。
・フィルターのお手入れには洗剤は使用せず、流水で表面の汚れを洗い流してください。
・夏場は虫が発生する可能性がありますので、毎日の洗浄をおすすめします。
・健康維持のため、フィルターは3週間から1ヶ月をめどに、または抜け毛やフードカスなどの目に見える汚れや変色が目立ってきたら交換してください。
・フィルター交換時には、清潔に保つために必ずファウンテン本体各部・ポンプを洗浄してください。
【規格概要】
| PP、イオン交換樹脂、活性炭 |
【注意事項】
・抗菌活性炭にはフィルターがピンク色になることを抑制する効果はありません。
・使用環境によってはフィルターがピンク色になる場合がありますが、ペットに害はありません。
・使用中、やや黄色がかった水が出ることがありますが、これはイオン交換樹脂の成分が溶出するためであり、品質には問題なく無害です。